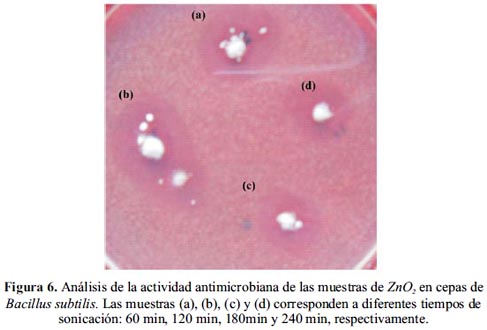

Servicios Personalizados
Revista
Articulo
Indicadores
-
 Citado por SciELO
Citado por SciELO
Links relacionados
-
 Similares en
SciELO
Similares en
SciELO
Compartir
Revista de la Sociedad Química del Perú
versión impresa ISSN 1810-634X
Rev. Soc. Quím. Perú vol.79 no.2 Lima abr./jun. 2013
TRABAJOS ORIGINALES
Síntesis de nanopartículas de ZnO2 empleando ultrasonido: caracterización estructural y morfológica para aplicaciones bactericidas
Nanoparticle synthesis of zinc peroxide: structural and morphological characterization for bactericidal applications
Roberto Coloniaa, Vanessa C. Martíneza, José L. Solísa, Mónica M. Gómez*a
a Facultad de Ciencias, Universidad Nacional de Ingeniería, Av. Túpac Amaru 210, Lima 25, Perú mgomez@uni.edu.pe
RESUMEN
El peróxido de zinc (ZnO2) fue sintetizado en forma de nanopartículas por medio de la ruta sol-gel por la que se obtuvo un gel particulado. Para la síntesis se empleó acetato de zinc di-hidratado (Zn(CH3COO)2.2H2O) y peróxido de hidrógeno (H2O2) al 30% en un medio acuoso sometido a sonicación. Las nanopartículas de ZnO2 obtenidas fueron caracterizadas estructuralmente mediante la técnica de difracción de rayos-X. Mientras que el estudio de la morfología y tamaño de conglomerados cristalinos del nanopolvo, se realizó por microscopía electrónica de transmisión y barrido. Para explorar las propiedades bactericidas del ZnO2 se realizó pruebas preliminares en las que se expuso este material a las cepas: Staphylococcus aureus, Escherichia coli y Bacillus subtili, y se obtuvo que las nanopartículas presentan buena propiedad bactericida.
Palabras clave: peróxido de zinc, nanopartículas, bactericida, sonicación.
ABSTRACT
Zinc peroxide (ZnO2) nanoparticles were synthesized by sol-gel technique. The chemicals used for the synthesis were zinc acetate di-hydrate (Zn(CH3COO)2.2H2O) and hydrogen peroxide (H2O2) at 30% in an aqueous solution with sonication. The structure of the ZnO2 nanoparticles was characterized by X-ray diffraction. While the morphology and the cluster size were determined using scanning and transmission electron microscopy. For a preliminary evaluation of the bactericidal properties of the ZnO2, the material was exposed to Staphylococcus aureus, Escherichia coli y Bacillus subtili, and the nanoparticles presented good bactericidal properties.
Key words: zinc peroxide, nanoparticles, bactericidal, sonication.
INTRODUCCIÓN
El ZnO2 es un polvo sin olor, de color blanco o ligeramente amarillento, casi insoluble en agua y soluble en ácido. El ZnO2 es un tipo de peróxido muy estable en condiciones normales, pero cuando llega a 150°C empieza a descomponerse y generar oxígeno, para formar ZnO.
El ZnO2 es un material semiconductor con un ancho de banda prohibida de 4,5 eV1, además, es ampliamente utilizado en la industria, tal como la del caucho2-4, el procesamiento de plásticos, como oxidante para explosivos y mezclas pirotécnicas5, y en los últimos años, en la industria cosmética y farmacéutica, como un aditivo antiséptico en el tratamiento de las enfermedades de la piel6-8. También el ZnO2 puede usarse en procesos de fotocatálisis9 y como precursor para la preparación de nanopartículas de ZnO10-12.
La preparación de ZnO2 es producida principalmente a partir de los siguientes reactivos: ZnO, Zn(OH)2, ZnEt2, Zn(NO3)2, ZnCl2 o ZnCO3.
En el presente artículo reportamos la síntesis de nanopartículas de ZnO2 mediante la técnica de sol-gel, empleando acetato de zinc di-hidratado Zn(CH3COO)2.2H2O y peróxido de hidrógeno (H2O2) al 30% en un medio acuoso. Durante la síntesis, el sol fue expuesto a sonicación13 durante diferentes periodos de tiempo.
PARTE EXPERIMENTAL
Síntesis de las nanopartículas de ZnO2
Para la síntesis de las nanopartículas de ZnO2 se utilizó la ruta sol-gel; para ello se preparó una solución precursora empleando 5ml de H2O2 al 30% con 50 ml de H2O y se dejó sonicar la solución por un periodo de 2 min. Luego se disolvió 1g de Zn(CH3COO)2.2H2O en la solución de H2O2, e igualmente se dejó sonicar por un periodo de 5 min hasta obtener una solución homogénea. Con esta solución se procedió a la sonicación de la solución precursora; para esto se posicionó el matraz dentro del sonicador de tal forma que se genere el mayor número de implosiones (figura 1).

Luego de un tiempo determinado de sonicación se centrifugó el coloide para poder separar las partículas del gel formadas. El proceso de centrifugación se realizó durante 20 min a 5000 rpm. Las partículas obtenidas fueron lavadas dos veces con agua destilada. Para secar el gel se dejó a 80°C durante 12 h.
Para la síntesis de las nanopartículas de ZnO2 se utilizó el sonicador ultrasónico marca Branson Modelo MT 1510 (42kHz, 75 W).
RESULTADOS Y DISCUSIÓN
Análisis de las nanopartículas de ZnO2
La caracterización estructural y morfológica de las nanopartículas es de gran importancia para interpretar sus propiedades, tanto físicas como químicas, y también lo será para poder explorar las aplicaciones microbiológicas que se puedan proponer. A continuación presentamos la investigación estructural llevada a cabo mediante difracción de rayos-X, el estudio morfológico realizado por microscopía electrónica de transmisión (MET) y microscopía electrónica de barrido (MEB). Finalmente se muestran las pruebas microbiológicas preliminares realizadas exponiendo las nanopartículas de ZnO2 a tres tipos de cepas de diferentes bacterias.
Difracción de rayos X
La caracterización estructural de las nanopartículas de ZnO2 se realizó por DRX empleando un difractómetro Rigaku Miniflex II Desktop operado con una fuente de radiación de CuKα (λ = 0,15045 nm) a 30 kV, 20 Ma y con una velocidad de barrido de 3°/min. La figura 2 muestra los datos obtenidos para las nanopartículas sintetizadas a diferentes tiempos de sonicación como se indica en la figura (30, 60 y 170 min). Como se puede observar, se presentan notoriamente tres picos anchos asignados a las reflexiones [111], [200] y [220] del ZnO2.1 Débilmente se registran dos protuberancias que corresponderían a las reflexiones [210] y [211] también asignados al ZnO2.1

Para el análisis de los difractogramas se utilizó el programa TOPAS-Academic14 que provee una aproximación general de la convolución y refinamiento de los datos con una variedad de perfiles numéricos, sin la necesidad de una convolución analítica. Esto se logra con funciones que representan, la fuente de rayos-X, la aberración del difractómetro (diámetro del goniómetro, si usa monocromador, rejillas, etc.), así como la contribución de la muestra (tamaño del cristalito y microdeformación). Este método es conocido como aproximación por parámetros fundamentales (APF).
En el presente trabajo todos los difractogramas pudieron ajustarse satisfactoriamente usando una sola fase correspondiente al ZnO2, que posee una estructura cúbica con grupo espacial Pa3 y parámetro de red de 4,874 Å, donde los átomos de Zn y O están localizados en las posiciones (0, 0, 0) y (0,413; 0,413; 0,413), respectivamente.1
Mediante el refinamiento de Rietveld15 y el APF se obtuvo para las tres muestras analizadas (30, 60 y 170 min) que el tamaño de cristalito promedio para las tres muestras fue de 10 nm, y la microdeformación fue 0,35; 0,27 y 0,25, respectivamente.
La figura 3 muestra los difractogramas obtenidos para las nanopartículas sintetizadas para los tiempos de sonicación indicados (60,120, 180, 240 y 300 min). De manera análoga a la figura anterior se presentan notoriamente los tres picos anchos antes identificados y asignados alZnO2, pero además, como las muestras fueron analizadas hasta 2θ igual a 70, también se pueden identificar las reflexiones [311] y [222] correspondientes al ZnO2. Débilmente también se identifican las dos pequeñas protuberancias que corresponderían a las reflexiones [210] y [211] asignadas al ZnO2.

Mediante el Refinamiento de Rietveld se obtuvo, para las cinco muestras analizadas (60,120, 180, 240 y 300 min), los siguientes tamaños de cristalito con sus respectivos valores de microdeformación indicados en paréntesis: 9 nm (0,31), 10 nm (0,32), 13 nm (0,28), 12 nm (0,23) y 14 nm (0,18), respectivamente.
Microscopía electrónica de transmisión
La morfología y también la estructura de las nanopartículas fueron estudiadas por MET empleando un microscopio Philips EM 400 operando a 80 kV en los modos imagen y difracción. Para su análisis, las nanopartículas fueron dispersadas en agua destilada.
La figura 4 muestra las micrografías de las muestras de nanopolvos sintetizados para diferentes tiempos de sonicación. Para cada una de las muestras se presenta en la esquina izquierda superior, el patrón de difracción obtenido. De esta información y luego de indexar los anillos, se obtuvo que todas las muestras corresponden al ZnO2.

Microscopía electrónica de barrido
Para el análisis morfológico de los nanopolvos de ZnO2 se utilizó microscopía electrónica de barrido usando un microscopio electrónico marca Jeol JSM-6300 operado con una aceleración de electrones de 5 kV.
La figura 5 muestra las imágenes para las partículas obtenidas para diferentes tiempos de sonicación. Las figuras 5a y 5b muestran dos magnificaciones diferentes (100 KX y 200 KX) que corresponden a un tiempo de sonicación del coloide de 30 min, mientras que análogamente las figuras 5c y 5d muestran las imágenes correspondientes a un coloide sonicado durante 60 min. Ambos materiales muestran conglomerados cristalinos esféricos de entre 100 y 200 nm, de una apariencia racimosa (similar al que en la naturaleza se observa en la frambuesa). Dichos conglomerados cristalinos están constituidos a su vez por nanopartículas mucho más pequeñas, que para la resolución de su tamaño, por este técnica no se puede determinar. Esta información es complementaria a la obtenida por DRX y MET, donde se determina el promedio y el tamaño directamente de cristalitos que conforman los conglomerados cristalinos que por MEB se puede apreciar claramente.

Evaluación de la actividad antimicrobiana
No se conoce una metodología para la evaluación de las propiedades bactericidas de los materiales nanoparticulados. El método más comúnmente utilizado en laboratorio por su sencillez y rapidez, es la técnica de difusión por discos en agar, que es utilizada para generar datos cualitativos.16 Esto se fundamenta en la inhibición del crecimiento bacteriano mediante la difusión de las nanopartículas de ZnO2 en un medio de cultivo sólido, el mismo que se evidencia con la formación de zonas claras o halos de inhibición.
Mediante esta técnica se realizó los estudios preliminares de la actividad antimicrobiana de las nanopartículas de ZnO2, para lo cual se empleó 3 cepas patógenas: Bacillus subtilis(ATCC 6051), Escherichia coli(ATCC 25922) y Staphylococcus aureus (ATCC 25923). Todas las pruebas de actividad antimicrobiana se realizaron incubando a una temperatura de 37 °C en una estufa por un tiempo de 24 h; luego de ese tiempo se procedió a medir los halos correspondientes.
Las figuras 6-8 muestran las imágenes de los análisis microbiológicos realizados para diferentes cepas. Para cada uno de los cultivos se colocó muestras de nanopartículas ZnO2 obtenidas a diferentes tiempos de irradiación ultrasónica: (a) 60 min, (b) 120 min (c) 180 min y (d) 240 min, respectivamente.
La figura 6 muestra los resultados obtenidos para las partículas de ZnO2 con cepas de Bacillus subtilis. Se puede observar en todas las muestras halos grandes (~ 10 mm) y opacos. La opacidad de los halos sería indicativo de un proceso parcial de crecimiento microbiano dentro de ellos, dado a que hay colonias resistentes al producto.
La figura 7 presenta la imagen del análisis obtenido para las partículas de ZnO2 con cepas de Escherichia coli. En este caso se observa anillos muy pequeños (~ 1-2 mm) pero limpios. Lo que sería indicativo de un débil proceso bactericida del producto.

Finalmente, la figura 8 muestra la imagen del análisis realizado para las partículas de ZnO2 en cepas de Staphylococcus aureus. En este caso se observa anillos muy grandes (~ 10 mm) y limpios. Lo que claramente mostraría una muy buena propiedad bactericida de las nanopartículas de ZnO2 ante estas cepas.

Según los análisis de DRX y MET se tiene que las nanopartículas sintetizadas por sonicación corresponden a una sola fase y es el ZnO2.
La síntesis de las nanoestructuras de ZnO2 debe proceder por medio de la siguiente reacción rédox:

Según los resultados de DRX, las dimensiones promedios de los cristalitos de ZnO2 está entre 9 y 14 nm; el tamaño se incrementa conforme se incrementa el tiempo de sonicación, mientras que la microdeformación disminuye. Según las micrografías SEM de las nanopartículas (figura 5) se observa que la distribución de los tamaños de los aglomerados es más uniforme a mayor tiempo de sonicación, pero a menor tiempo de sonicación se tiene conglomerados muy pequeños (~30 nm) y algunos de mayor tamaño (~200 nm).
Todas las nanopartículas de ZnO2 tienen actividad antimicrobiana; sin embargo se puede observar que las nanopartículas de ZnO2 obtenidas con tiempo de sonicación de 60 min son las que presentan la mejor actividad antimicrobiana, la cual se hace cada vez menor conforme el tiempo de sonicación se incrementa. Es posible que esto se deba a que el tamaño promedio de los cristalitos se incrementa a mayor tiempo de sonicación y la microdeformación disminuye. La disminución de la microdeformación está relacionada a que el material tiene menos defectos; lo que sería un indicativo de que el tamaño y los defectos del material son muy importantes para la determinación de su propiedad bactericida.
CONCLUSIONES
Nanopartículas de ZnO2 fueron sintetizadas por la ruta sol-gel empleando como agente externo radiación sonoquímica. El tamaño de los cristalitos determinado por DRX fue entre 9 y 14 nm con una presencia de microdeformación que disminuye a medida que el tiempo de sonicación aumenta. Las partículas se encuentran conglomeradas en esferas que muestran una apariencia racimosa con tamaños entre 100 y 200 nm. Las nanopartículas evaluadas cualitativamente ante las cepas patógenas seleccionadas presentaron una gran actividad antimicrobiana para el Staphylococcus aureus.
AGRADECIMIENTO
Los autores agradecen a la bióloga Kety León por los análisis microbiológicos, al Dr. Alcides López por los análisis de microscopía electrónica de transmisión y al Dr. Alec Fischer por los análisis de microscopía electrónica de barrido. Uno de nosotros (R.C.) agradece al Instituto General de Investigación de la Universidad Nacional de Ingeniería (IGI-UNI) por la beca otorgada.
El presente trabajo fue desarrollado bajo el auspicio del Consejo Nacional de Ciencia, Tecnología e Innovación Tecnología del Perú (CONCYTEC) y del Instituto General de Investigación de la Universidad Nacional de Ingeniería (IGI).
BIBLIOGRAFÍA
1. W. Chen, Y.H. Lu, M. Wang, L. Kroner, H. Paul, Synthesis, Thermal Stability and Properties of ZnO2 Nanoparticles. J. Phys. Chem. C. 2009; 113: 1320-1324.
2. Ibarra, L., Alzorriz, M. Effect of Temperature on the Crosslink Densities of Nitrile Rubber and Carboxylated Nitrile Rubber with Zinc Peroxide. J. Appl. Polym. Sci 2002; 86: 335–340.
3. L. Ibarra, A. Marcos-Fernández, M. Alzorriz, Mechanistic approach to the curing of carboxylated nitrile rubber (XNBR) by zinc peroxide/zinc oxide, Polymer 2002; 43: 1649-1655.
4. L. Ibarra, M. Alzorriz, Ionic Elastomers Based on Carboxylated Nitrile Rubber (XNBR) and Zinc Peroxide: Influence of Carboxylic Group Content on Properties, J. Appl. Polym. Sci 2002; 84: 605-615.
5. R. Hagel, Verwendung von Zinkperoxid als Oxidationsmittel für Sprengstoffe und Pyrotechnische Gemische 1984.
6. F. L. Meleney, H. D. Harvey, The Combined use of zinc peroxide and sulfanilamide in the treatmnet of chronic, undermining, burrowing ulcers due to the micro-Aerophilic Hemolytic Streptococcus. Annals of Surgery 1939; 1067-1094.
7. F.L. Meleney, Zinc Peroxide in Surgical Infections. The American Journal of Nursing 1941; 41: 645-649.
8. B.A. Johnson, F.L. Meleney, The antiseptic and detoxifying action of zinc peroxide on certain surgical aerobic, anaerobic and micro-Aerophilic Bacteria. Annals of Surgery 1939; 109.
9. C.-C. Hsu, N. L.Wu, Synthesis and photocatalytic activity of ZnO/ZnO composite. J. Photochem. Photobiol. 2005; A 172: 269–274.
10. M. Sun, W. Hao, C. Wang, T.A. Wang, Simple and green approach for preparation of ZnO and ZnO under sunlight irradiation. Chem. Phys. Lett. 2007; 443: 342–346.
11. N. Uekawa, J. Kajiwara, N. Mochizuki, K. Kakegawa, Y. Sasaki, Synthesis of ZnO Nanoparticles by Decomposition of Zinc Peroxide. Chem. Lett, 2001; 606-607.
12. N. Uekawa, N. Mochizuki, J. Kajiwara, F. Mori, Y.J. Wu Jun, K. Kakegawa, Nonstoichiometric properties of zinc oxide nanoparticles prepared by decomposition of zinc peroxide. Phys. Chem. Chem. Phys. 2003; 5: 929–934.
13. C. N. R. Rao, A. Müller, A. K. Cheetham, The Chemistry of Nanomaterials: Synthesis, Properties and Applications, Wiley-VCH, 2004.
14. R. W. Cheary, A. A. Coelho,A Fundamental Parameters Approach to X-ray Line-Profile Fitting. J. Appl. Cryst 1992; 25: 109-121.
15. R. A. Young, The Rietveld Method, Oxford University Press, 2002.
16. J. Chapman, T. Sullivan, F. Regan, Nanoparticles in Anti-Microbial Materials, The Royal Society of Chemistry, 2012.
Recibido el 22-03-2013
Aprobado el 29-04-2013













